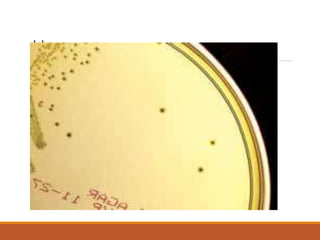
H e agar
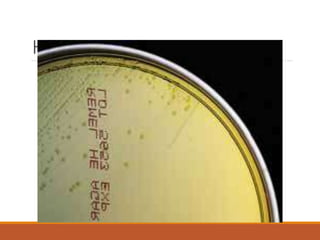
H e agar
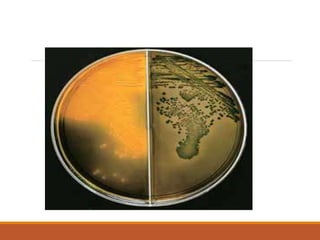

The document discusses various selective media used for the isolation and differentiation of specific bacteria, including MacConkey agar, EMB agar, MSA, and XLD agar. Each medium has unique components that selectively inhibit certain organisms while allowing others to grow, as well as indicators for fermentation results. Additionally, it touches on the importance of pH in biological processes, including the use of buffers to maintain optimal conditions for enzyme activity and cell functions.

![How buffers work
Equilibrium between acid and base.
Example: Acetate buffer
◦ CH3COOH CH3COO- + H+
If more H+ is added to this solution, it simply shifts the equilibrium to
the left, absorbing H+, so the [H+] remains unchanged.
If H+ is removed (e.g. by adding OH-) then the equilibrium shifts to the
right, releasing H+ to keep the pH constant](https://image.slidesharecdn.com/selectivemedia-240710055752-4e4a2c7d/85/Selective-media-types-Composition-andpplications-43-320.jpg)

![Calculating buffer recipes
Henderson-Hasselbach equation
◦ pH = pKa - log10 [acid]/[base]
Rearrange the equation to get
◦ 10(pKa-pH) = [acid]/[base]
Look up pKa for acid in a table. Substitute this and the desired pH into
equation above, and calculate the approximate ratio of acid to base.
Because of the log, you want to pick a buffer with a pKa close to the pH
you want.](https://image.slidesharecdn.com/selectivemedia-240710055752-4e4a2c7d/85/Selective-media-types-Composition-andpplications-45-320.jpg)

